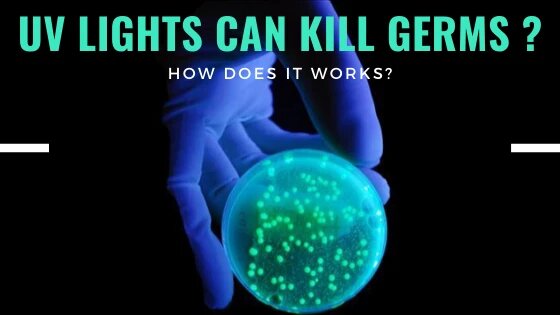

隨著因新型冠狀病毒而不斷提高的衛生意識,許多公司都在市場上推出了各種不同的紫外線殺菌產品,我們來深入了解一下其原理。
就紫外線消毒而言,並非所有種類的紫外線都適用。參考資料指出,紫外線(UV)可以分為三個波段,分別是UVA,UVB和UVC,分別於減小的波長和增加的能量。就紫外線消毒而言,只有紫外線(100-280nm)具有最高的功率,足以殺死包括病毒和細菌在內的微生物。因此,當您決定將紫外線消毒產品作為日常用品使用時,請記住確保紫外線燈的波長在100-280nm之間。
單擊此處以獲取有關紫外線的更多信息。

1877年,研究發現UVC具有殺菌和抑菌作用。毫無疑問,紫外線殺菌是無價的且不斷改進的解決方案,其強大的功能可防止感染的傳播。最常見的例子是利用紫外線於創建乾淨工作空間的醫學領域有關。
物件表面的細菌將被紫外線殺菌輻射(UVGI)殺死。它能夠通過破壞其DNA分子的結構使微生物失活,使其無法繁殖並阻止繁殖,不再具有傳染性。供您參考,紫外線的DNA吸收峰為260 nm,該波長在UVC波長(100-280nm)範圍內。但是,殺菌的UVC燈可淨化大多數細菌的99%。

長期的調查研究表明,如果安裝正確,UVGI在消毒領域是安全有效的,從而可以抑制多種空氣傳播感染的播體。從長遠來看,儘管UVC燈直接暴露於皮膚或眼睛會造成暫時的不良反應,但在正確安裝的情況下,它絕不會造成任何永久性損壞。
紫外線燈適用於哪些滅菌應用?
醫療用途-用於醫院不同房間的消毒系統和廣泛的設施。

家用-用於物體表面滅菌和空氣消毒的UVC殺菌燈。